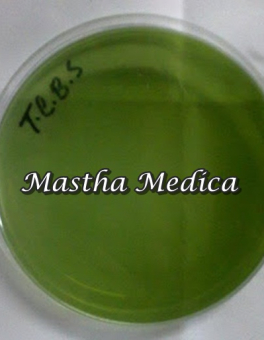

● online
Halo, perkenalkan saya CS mastha
baru saja
Ada yang bisa saya bantu?
baru saja
Hot Item
- Jual Handscoon Sarung Tangan Steril Maxter Box....
- Timbangan Dapur 100 Gram Motif Hello Kitty Merah....
- Bagaimana Cara Bermain Rolet Untuk Pemula....
- Daftar Slot Online Pakai Dana....
- Jual Tensimeter Aneroid Jarum ABN Palm....
- Permainan Kasino Virtual Terbaik Online....
- Blackjack Uang Nyata 2025....
- Android Kasino Dengan Gratis 2025....
Jual Media Tumbuh Thiosulfate Citrate Bile Salt Sucrose Plate TCBS 1 Pack
NB : UNTUK PENGIRIMAN WAJIB MENGGUNAKAN EKSPEDISI JNE YES Ik Media Tumbuh Thiosulfate Citrate Bile Salt Sucrose Plate TCBS 1 Pack Tcbs merupakan media selektif yang digunakan untuk isolasi spesies vibrio dari specimen berak ( stool) yang mengaduk bakteri campuran. Spesifikasi : – Nama : Thiosulfate Citrate Bile Salt Sucrose Plate – jenis :… selengkapnya
Rp 800.000 Rp 1.250.000 Pre Order